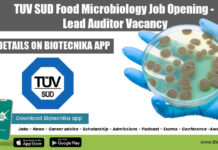
TUV SUD Food Microbiology Job Opening – Lead Auditor Vacancy TUV SUD Food Microbiology

ACTREC Cancer Project Job For Life Sciences With Rs. 43,400 pm Pay
ACTREC Cancer Project Job For Life Sciences With Rs. 43,400 pm Pay
ACTREC Cancer Project Job For Life Sciences With Rs. 43,400 pm Pay. MSc...
Tocklai Tea Research Life Sciences Tech Assistant Job Openings, Applications Invited
Tocklai Tea Research Jobs For Life Sciences - Applications Invited
Tocklai Tea Research Jobs For Life Sciences - Applications Invited. Tea Research Institution is hiring...
Pfizer Associate Job Recruitment For Microbiology, Apply Online
Pfizer Associate Job Recruitment For Microbiology, Apply Online
Pfizer Associate Job Recruitment For Microbiology, Apply Online. Pfizer is hiring candidates for an Associate -Microbiology vacancy....
Government RGCB DBT Funded Project JRF Job For Life Sciences, Biotech, Biochem & Zoology
RGCB JRF Vacancy 2022 - Biotech, Biochem, Zoology & Life Sciences
RGCB JRF Vacancy 2022 - Biotech, Biochem, Zoology & Life Sciences. Rajiv Gandhi Centre...
Govt ILS NGS Data Analyst, QC Consultant Jobs For Life & Biological Sciences
Government ILS Jobs Latest - Biological & Life Science Apply
Government ILS Jobs Latest - Biological & Life Science Apply. MSc, MTech, BSc, PhD biological...
FRESHERS Govt Indian Pharmacopoeia Commission (IPC) Jobs 2022
Freshers Govt Jobs 2022 at Indian Pharmacopoeia Commission (IPC)
Freshers Govt Jobs 2022 at Indian Pharmacopoeia Commission (IPC). Government jobs for MSc Biochemistry. Indian Pharmacopoeia...
Student Internship With Stipend For MTech, MSc, BTech at CSIR-IITR
Student Internship With Stipend For MTech, MSc, BTech at CSIR-IITR
Student Internship With Stipend For MTech, MSc, BTech at CSIR-IITR. CSIR - Indian Institute of...
Biotecnika Times Newsletter 28.04.2022 FSSAI Internship, Govt OMFED QC Jobs, ICAR
Biotecnika Times - FSSAI Internship, Govt OMFED QC Jobs, ICAR
FSSAI Internship Scheme For May 2022 With Stipend, APPLICATION PORTAL OPEN
FSSAI Internship 2022 May Scheme,...
NCCS Pune Job 2022 – Research Associate, JRF & Project Associate Vacancies
NCCS Pune Job 2022 - Research Associate, JRF & Project Associate Vacancies
NCCS Pune Job 2022 - Research Associate, JRF & Project Associate Vacancies. NCCS...
ICAR Indian Institute of Millets Research Recruitment With Rs. 80,000 pm Pay
ICAR Millets Research Recruitment With Rs. 80,000 pm Pay
ICAR Millets Research Recruitment With Rs. 80,000 pm Pay. ICAR – Indian Institute of Millets Research...
WII Life Sciences & Botany Project Recruitment, Applications Invited
WII Project Vacancies 2022 For Life Sciences, Botany - Applications Invited
WII Project Vacancies 2022 For Life Sciences, Botany - Applications Invited. MSc & PhD...
TUV SUD Food Microbiology Job Opening – Lead Auditor Vacancy
TUV SUD Food Microbiology Job Opening - Lead Auditor Vacancy
TUV SUD Food Microbiology Job Opening - Lead Auditor Vacancy. Interested and eligible applicants can...
CSIR-CFTRI Project Job Opening For Biotech, Biochem & Microbiology
CSIR-CFTRI Project Job Opening For Biotech, Biochem & Microbiology
CSIR-CFTRI Project Job Opening For Biotech, Biochem & Microbiology. CSIR-CFTRI Job Openings. MSc Biotech, Biochem and...
CFTRI Online Project Recruitment For Biochem & Food Sciences
CFTRI Online Project Recruitment For Biochem & Food Sciences
CFTRI Online Project Recruitment For Biochem & Food Sciences. CSIR-CFTRI Job Openings. MSc Biochem and Food...
CSIR-IMTECH Microbial Engineering Technology Project Associate Recruitment, Apply Online
IMTECH Job Opening 2022 - Project Associate Job Available
IMTECH Job Opening 2022 - Project Associate Job Available. Project Associate Recruitment. Interested and eligible applicants...